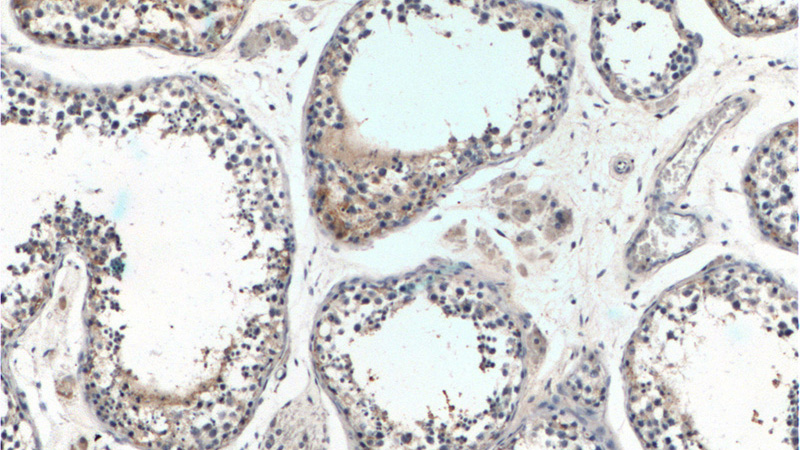
Immunohistochemistry of paraffin-embedded human testis tissue slide using Catalog No:109912(DGKH Antibody) at dilution of 1:200 (under 10x lens).

-
Product Name
DGKH antibody
- Documents
-
Description
DGKH Rabbit Polyclonal antibody. Positive IP detected in mouse brain tissue. Positive WB detected in mouse brain tissue. Positive IHC detected in human testis tissue. Positive IF detected in SH-SY5Y cells. Observed molecular weight by Western-blot: 135 kDa
-
Tested applications
ELISA, WB, IP, IF, IHC
-
Species reactivity
Human,Mouse,Rat; other species not tested.
-
Alternative names
DAG kinase eta antibody; DGK eta antibody; DGKeta antibody; DGKH antibody; Diacylglycerol kinase eta antibody; diacylglycerol kinase antibody; eta antibody; Diglyceride kinase eta antibody; DKFZp761I1510 antibody
-
Isotype
Rabbit IgG
-
Preparation
This antibody was obtained by immunization of DGKH recombinant protein (Accession Number: NM_001204505). Purification method: Antigen affinity purified.
-
Clonality
Polyclonal
-
Formulation
PBS with 0.02% sodium azide and 50% glycerol pH 7.3.
-
Storage instructions
Store at -20℃. DO NOT ALIQUOT
-
Applications
Recommended Dilution:
WB: 1:500-1:5000
IP: 1:200-1:2000
IHC: 1:50-1:500
IF: 1:50-1:500
-
Validations

mouse brain tissue were subjected to SDS PAGE followed by western blot with Catalog No:109912(DGKH antibody) at dilution of 1:300

IP Result of anti-DGKH (IP:Catalog No:109912, 5ug; Detection:Catalog No:109912 1:500) with mouse brain tissue lysate 2640ug.
Immunohistochemistry of paraffin-embedded human testis tissue slide using Catalog No:109912(DGKH Antibody) at dilution of 1:200 (under 10x lens).

Immunohistochemistry of paraffin-embedded human testis tissue slide using Catalog No:109912(DGKH Antibody) at dilution of 1:200 (under 40x lens).

Immunofluorescent analysis of (-20oc Acetone) fixed SH-SY5Y cells using Catalog No:109912(DGKH Antibody) at dilution of 1:50 and Alexa Fluor 488-congugated AffiniPure Goat Anti-Rabbit IgG(H+L)
-
Background
DGKH(Diacylglycerol kinase eta) is also named as DGK-eta and belongs to the eukaryotic diacylglycerol kinase family. It is a key protein in the lithium-sensitive phosphatidyl inositol pathway, and more recently a link between environmental stress and schizophrenia and possibly bipolar disorder has been revealed. DGKH has 3 isoforms produced by alternative splicing.Two isoforms DGKH1 and DGKH2 with the molecular weight of 128 kDa and 135 kDa shows diacylglycerol kinase activity; however, the 2 isoforms differed in several other characteristics(PMID:12810723).
-
References
- Nakano T, Iravani A, Kim M. Diacylglycerol kinase η modulates oncogenic properties of lung cancer cells. Clinical & translational oncology : official publication of the Federation of Spanish Oncology Societies and of the National Cancer Institute of Mexico. 16(1):29-35. 2014.
- Usuki T, Sakai H, Shionoya T, Sato N, Sakane F. Expression and localization of type II diacylglycerol kinase isozymes δ and η in the developing mouse brain. The journal of histochemistry and cytochemistry : official journal of the Histochemistry Society. 63(1):57-68. 2015.
- Shionoya T, Usuki T, Komenoi S, Isozaki T, Sakai H, Sakane F. Distinct expression and localization of the type II diacylglycerol kinase isozymes δ, η and κ in the mouse reproductive organs. BMC developmental biology. 15:6. 2015.
- Kawaguchi M, Valencia JC, Namiki T, Suzuki T, Hearing VJ. Diacylglycerol kinase regulates tyrosinase expression and function in human melanocytes. The Journal of investigative dermatology. 132(12):2791-9. 2012.
Related Products / Services
Please note: All products are "FOR RESEARCH USE ONLY AND ARE NOT INTENDED FOR DIAGNOSTIC OR THERAPEUTIC USE"
